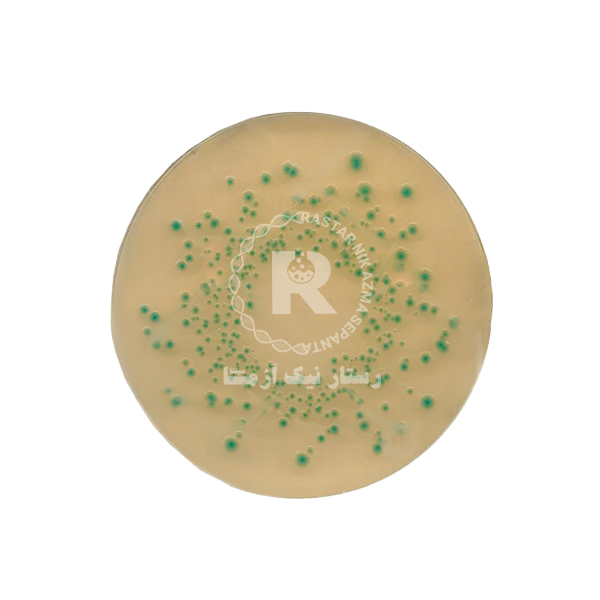
تريپتون بايل آگار TBA 100G -كيولب

مشخصات محصول:
محیط کشت Tryptone Bile Agar یا TBA اولین بار بر اساس فرمول کشف شده توسط اندرسون و پارکر توسعه یافت. این محیط کشت برای شناسایی اشرشیا کلی موجود در مواد غذایی و شمارش آن ها به کار می رود. محیط کشت TBA حاوی نمک، تریپتون، آگار وآب مقطر است. از جمله فواید استفاده از این محیط کشت به تغییر پذیری کمتر، تشخیص سویه های بی هوازی و ضعیف تر، دریافت سریعتر نتیجه و ارائه ریکاوری بهتری از نمونه های فریز شده می توان اشاره کرد.
محیط کشت Tryptone Bile Agar چه ویژگی هایی دارد؟
محیط کشت تریپتون بایل آگار در جهت تشخیص سریع اشرشیا کلی های موجود در آب و غذا به کار می رود. این محیط کشت بر اساس فیلتراسیون غشایی عمل می کند و شامل ویتامین ها، اسید های آمینه، مواد معدنی و نیتروژن مورد نیاز برای رشد و کشت اشریشیا کلی را فراهم می کند. باکتری ها در این محیط از طریق سلولز در دمای 44 درجه سانتی گراد رشد می کنند.
سیستم عملکرد این محیط کشت به صورتی است که سایر میکروارگانیسم ها غیر از اشریشیا کلی را از بین می برد. یکی از مواد غذایی که به کمک این روش و فقط با بررسی میزان کمی از نمونه مورد بررسی قرار می گیرد، گوشت است. مدت زمان لازم برای دستیابی به نتیجه کشت، 18 تا 24 ساعت است.
در استفاده از محیط کشت Tryptone Bile Agar باید به چه نکاتی توجه نمود؟
یکی از نکاتی که در استفاده از محیط کشت باید در نظر داشته باشید، مطالعه دقیق برچسب روی محصول است. علاوه بر این در حین استفاده بهتر است از دستکش، لباس محافظ و همین طور محافظ هایی برای چشم و صورت خود استفاده کنید. به طور کلی باید در استفاده از نمونه ها کلیه نکات ایمنی و بهداشتی را رعایت کنید تا از انتشار میکروب و بیماری جلوگیری شود. توصیه می کنیم قبل از استفاده از محصول حتما برچسب روی محصول و دستورالعمل های ضروری را مطالعه کنید.